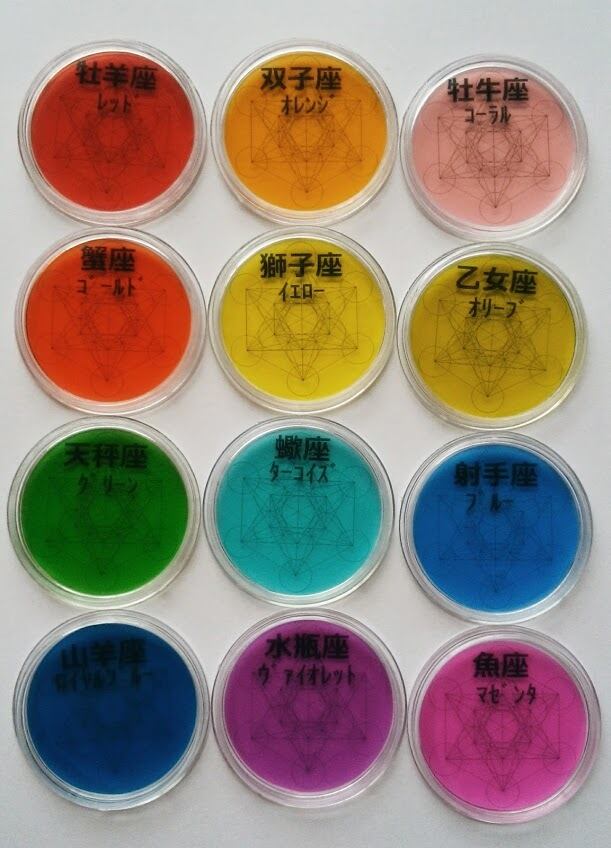

1/20
天体色数鑑定セット
¥19,800
International shipping available
天体色数の鑑定セットです。
このセットで、個人鑑定、日々の天体色数、選択色数鑑定が行なえます。
送料込みの価格です。
【セット内容】
・スピリットカラーパレット 84枚(12星座のカラーパレットを各7枚ずつ)
(直径約3cm)*箱はつかない場合もございますのでご了承ください。
・水晶入りナンバー大ボトル 48本(1~12までの数字ボトルを各4本ずつ)
(高さ約3.5cm)
・円形数字フィルム 1枚
・天体色数図シートA4サイズ 1枚
・A4サイズ・高さ3cmの大きさでポストにお届けとなります。
-
レビュー
(3)
最近チェックした商品
その他の商品